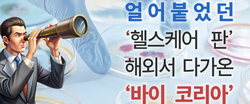

투자 요인은 코로나 이후 높아진 헬스케어 관심+매력적 K-파이프라인
얼어붙은 헬스케어... 해외서 다가온 '바이 코리아'(Buy Korea)
세계 자본이 국내 헬스케어 기업을 향해 움직이고 있다. 국내 기업의 연이은 기술이전 실적과 상대적 저평가 속에 우리나라 생태계가 관심을 받는 것으로 풀이된다. 반면 해외 투자가 향후 우리 기술의 유출로 이어질 수 있다는 우려도 나온다. 해외 투자 움직임과 국내 업계 목소리를 담아본다.
① 해외는 왜, 국내 헬스케어를 바라볼까
② 보는 눈이 많아야 돈도 몰린다
일본 다이와증권그룹 내 야마토기업투자의 대주주인 DCI파트너스는 자사가 운용하는 3호 헬스케어 펀드에 기존 일본과 대만에 이어 한국 기업을 물색하는 작업에 들어갔다. 일본 소프트뱅크 계열 VC가 다양한 기업에 투자를 한 사례는 있지만, 헬스케어 분야만 전담하는 일본 기업이 한국에 직접 투자를 결정한 것은 사실상 처음이다.
이들은 수 개월에 걸쳐 국내 다수의 바이오텍을 직접 만나면서 한국의 생태계는 물론 개별 기업의 기술적 가치를 확인하고 향후 투자를 결정한다는 계획이다. 상장 과정이 쉽지 않은 일본에서도 기술적 가치가 높은 '그로스 시장'에 여러 기업을 상장시킨 전례가 있는 데다가 단순 기업 투자 뿐만이 아닌 인허가 및 임상 디자인 등을 비롯한 여러 경험이 있는 만큼 실제 투자가 이뤄질 경우 여러 지원도 따라올 가능성이 있다.
이 뿐만이 아니다. 최근 업계에서 투자 논의 이야기가 나오는 대상만 일본 및 중국 등을 포함해 여러 곳에 달한다는 이야기도 나오고 있다. 이들 모두 헬스케어 분야를 중점 투자하는 회사들인 만큼 이들 기업의 움직임은 이야기 만으로도 흥미를 끈다. 실제 최근 <히트뉴스>가 취재한 '바이오재팬 2024'에서도 해외 여러 기업과 투자청 등과 수차례 미팅이 이어졌다. 이들은 한국의 신약 개발 생태계와 더불어 국내 기업 의 신 모달리티 등을 봤다는 것이 참석한 관계자들의 후문이었다.
이런 가운데 최근 해외 자본의 본격 투자 사례도 생겼다. 웨이센은 지난 18일 스파크랩그룹의 사우디펀드 국내 1호 투자 기업으로 선정됐다고 밝혔다. 웨이센은 지난 2월 사우디아라비아 의료전문 기업인 메가마인드와 손잡고 자사의 인공지능 내시경 제품인 '웨이메드 엔도'를 판매하고 있다. 사우디아라비아는 지난 3월 총 400억달러, 우리돈 약 54조원 상당의 인공지능 대규모 투자 계획을 발표했는데 스파크랩과 손잡고 5000만달러 규모의 AIM-X 프로젝트를 발표한 바 있다. 여기에 실제 사우디아라비아 쪽 타 그룹에서 투자 관련 상담을 진행했다는 이야기도 나온다.
지난해 6월 디지털 헬스케어 스타트업인 엔도헬스는 미국 VC 앤드리슨 호로위츠 등으로부터 프리시드 투자를 받은 바 있다. 금액이 크진 않지만 미국에서 직접 투자를 받는 사례로 주목받은 바 있다.
이같은 분위기는 지난해와 다소 다른 양상이라는 것이 업계 관계자들의 말이다. 해외 투자 관련 상담 등은 과거에도 여러 번 있었지만 진전된 논의 수준은 아니었다. 반면 올해 투자 분위기는 예년보다 더 뜨거운 듯 하다. 한 바이오기업 관계자는 "기술을 단순히 알아보려는 것보다 좀 더 직접적으로 기업의 상황이나 한국의 생태계 전반에서 기업이 차지하는 위치 등을 묻는 질문도 있었다"며 "해외 시장이 좀 더 적극적이라는 느낌을 주는 것이 사실"이라고 말했다.
다른 바이오기업 관계자는 "그동안 일본이나 대만 쪽으로 옮겨갔던 분위기가 한국을 좀 더 눈여겨보고 있다는 느낌이 든다. 특히 국가 차원에서 기업들을 향한 선호가 높아진 것으로 보인다"고 전했다.

코로나19 분위기 탄 '한국 바이오'
"정보도, 평가도 없었지만…" 투자 물때 맞았다
투자 분위기가 좋아지는 데는 해외 시장이 코로나19 이후 헬스케어 분야의 중요성을 더 크게 느끼고 있기 때문이라는 이야기가 먼저 나온다. 현재 국가 차원에서 국내 기업의 유치를 원하는 곳은 중국, 이탈리아, 인도, 일본, 캐나다, 스페인 등 다양하다. 미국만 해도 9개 연방부처 협력을 통해 바이오산업을 키우기 위한 '국가바이오경제위원회'를 출범시키며 산업을 집중 육성하고 있다. 공적 연구는 ARPA-H 등의 각종 프로젝트로 키우고 있는 만큼 이제는 산업적 영역의 발전을 도모하겠다는 뜻이다.
유럽 역시 유럽연합 국가별 바이오기술법 제정을 검토하고 올해 미국, 인도, 한국, 일본 등과 바이오기술 및 제조 파트너십을 출범한다는 계획을 밝힌 바 있다. 유럽연합 차원의 국가바이오위원회의 출범도 밝히며 바이오시밀러 등 유럽연합 내 주요 산업을 더욱 활성화하겠다는 뜻이다.
이 과정에서 한국을 주목하는 두 번째 이유가 나온다. 동아시아권에서 생물보안법으로 인한 미중 관계 문제를 해결할 수 있는 데다가 기술력에도 불구하고 교수 창업 비율이 낮은 일본 대신 그 기술을 활용한 실제 신약 개발 능력과 인프라, 교수 창업 등 산업화 성향이 강한 한국 시장에 투자를 하면서 자연스럽게 그에 따른 수익을 거둘 수 있을 것이라는 이유에서다.
신약 기술 수출의 영향으로 한국 기업들의 파이프라인이 인정받았다는 분석도 나온다. 2023년 한국제약바이오협회 기준 7조9000억원 이상 규모로 기술수출이 이뤄졌으며 올해도 오름테라퓨틱과 리가켐바이오, 넥스아이 등이 상업화 기준 대규모 기술 수출에 성공하며 자연스럽게 한국 시장을 보는 업계의 인식이 바뀌었다는 것이다.
이런 분위기는 국내 기업이 기술 면에서 인정 받았음에도, 정작 기업 가치는 평가 절하돼 있다는 해외 관계자들의 말로 이어진다. 최근 만난 해외 한 투자기업 관계자는 "투자 업계는 그동안 한국의 신약개발 붐을 알고 있었지만 정보가 없고, 이를 입증할 수 있는 기록을 어떻게 봐야 하냐라는 문제가 있었다"며 "그러나 ADC부터 디지털 헬스케어까지 다양한 기업이 (기술수출) 실적을 거두면서 한국을 향한 관심이 좀 더 커진 것으로 보인다"고 말했다.
무엇보다 2023년 국내를 비롯해 세계적으로 얼어붙었던 투자심리가 해외 주식시장 등의 영향으로 다시 수혜를 입기 시작했고 이와 관련한 자본 역시 자연스럽게 움직이면서 한국을 향하게 하는 계기로 작용했다는 평가다.
다국적 제약사 본사 한 관계자는 "한국의 헬스케어 시장에 손이 갈 만한 상황이 (해외 투자자들에게) 생겼다고 본다"며 "한국 시장을 향한 관심이 높아지면서 이들과 함께 손을 잡고 투자를 통해 수익으로 연결하려는 움직임은 이어지지 않을까 싶다"고 전했다.
관련기사
- K-메디테크 부활 조짐...AI 기반 디지털 전환 투자매력 상승
- HIT 분석 | 큐어버스 기술이전 주역 CV-01 L/O의 매력
- 단독 | 日 헬스케어 최대급 VC DCI파트너스, 한국 투자 뛰어든다
- 웨이센, 스파크랩 사우디펀드 1호 투자 기업 선정
- 바이오 투자절벽 넘었더니…'확' 바뀐 R&D 패턴에 CRO 희비
- 외국 자본에 매력 발산하는 K-바이오텍들... "마냥 웃기 전 비판적 사고 필요"
- South Korean CRO Sector Struggles to Benefit from Investment Recovery
- 제약바이오협회, 스위스 바젤서 글로벌 네트워킹 행사 열어
- "바이오, 힘든 시기 한 번 남았다... 투심 올해말 바뀔 듯"

